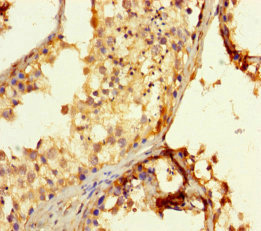

EXOSC3 Antibody
-
中文名稱:EXOSC3兔多克隆抗體
-
貨號:CSB-PA889083LA01HU
-
規格:¥440
-
圖片:
-
其他:
產品詳情
-
產品名稱:Rabbit anti-Homo sapiens (Human) EXOSC3 Polyclonal antibody
-
Uniprot No.:
-
基因名:
-
別名:EXOSC3 antibody; RRP40 antibody; CGI-102Exosome complex component RRP40 antibody; Exosome component 3 antibody; Ribosomal RNA-processing protein 40 antibody; p10 antibody
-
宿主:Rabbit
-
反應種屬:Human
-
免疫原:Recombinant Human Exosome complex component RRP40 protein (2-275AA)
-
免疫原種屬:Homo sapiens (Human)
-
標記方式:Non-conjugated
本頁面中的產品,EXOSC3 Antibody (CSB-PA889083LA01HU),的標記方式是Non-conjugated。對于EXOSC3 Antibody,我們還提供其他標記。見下表:
-
克隆類型:Polyclonal
-
抗體亞型:IgG
-
純化方式:>95%, Protein G purified
-
濃度:It differs from different batches. Please contact us to confirm it.
-
保存緩沖液:Preservative: 0.03% Proclin 300
Constituents: 50% Glycerol, 0.01M PBS, PH 7.4 -
產品提供形式:Liquid
-
應用范圍:ELISA, IHC
-
推薦稀釋比:
Application Recommended Dilution IHC 1:20-1:200 -
Protocols:
-
儲存條件:Upon receipt, store at -20°C or -80°C. Avoid repeated freeze.
-
貨期:Basically, we can dispatch the products out in 1-3 working days after receiving your orders. Delivery time maybe differs from different purchasing way or location, please kindly consult your local distributors for specific delivery time.
-
用途:For Research Use Only. Not for use in diagnostic or therapeutic procedures.
相關產品
靶點詳情
-
功能:Non-catalytic component of the RNA exosome complex which has 3'->5' exoribonuclease activity and participates in a multitude of cellular RNA processing and degradation events. In the nucleus, the RNA exosome complex is involved in proper maturation of stable RNA species such as rRNA, snRNA and snoRNA, in the elimination of RNA processing by-products and non-coding 'pervasive' transcripts, such as antisense RNA species and promoter-upstream transcripts (PROMPTs), and of mRNAs with processing defects, thereby limiting or excluding their export to the cytoplasm. The RNA exosome may be involved in Ig class switch recombination (CSR) and/or Ig variable region somatic hypermutation (SHM) by targeting AICDA deamination activity to transcribed dsDNA substrates. In the cytoplasm, the RNA exosome complex is involved in general mRNA turnover and specifically degrades inherently unstable mRNAs containing AU-rich elements (AREs) within their 3' untranslated regions, and in RNA surveillance pathways, preventing translation of aberrant mRNAs. It seems to be involved in degradation of histone mRNA. The catalytic inactive RNA exosome core complex of 9 subunits (Exo-9) is proposed to play a pivotal role in the binding and presentation of RNA for ribonucleolysis, and to serve as a scaffold for the association with catalytic subunits and accessory proteins or complexes. EXOSC3 as peripheral part of the Exo-9 complex stabilizes the hexameric ring of RNase PH-domain subunits through contacts with EXOSC9 and EXOSC5.
-
基因功能參考文獻:
- This is the first case of mitochondrial dysfunction associated with an EXOSC3 mutation, which expands the phenotypic spectrum of pontocerebellar hypoplasia type 1b. PMID: 28687512
- Mutations of EXOSC3/Rrp40p associated with pontocerebellar hypoplasia with progressive cerebral atrophy impact ribosomal RNA processing functions of the exosome in S. cerevisiae. PMID: 28053271
- EXOSC3 mutations were linked to complicated hereditary spastic paraplegia. PMID: 25149867
- study identified new nonsense and missense mutations in the EXOSC3 gene and showed mutations in this gene are exclusively found in pontocerebellar hypoplasia type 1 patients; there are evident genotype-phenotype correlations in EXOSC3-mediated PCH reflected in clinical outcome, age of death and pons hypoplasia PMID: 24524299
- The same mutation c.92G-->C, p.G31A in EXOSC3 was found in three unrelated Czech Roma patients with Pontocerebellar hypoplasia type 1 PMID: 23883322
- The present study indicates that EXOSC3 mutations can underlie clinical phenotype not classifiable as pontocerebellar hypoplasia type 1. PMID: 23975261
- We identified a homozygous mutation [c.395A > C/p.D132A] in EXOSC3 in four patients with muscle hypotonia, developmental delay, spinal anterior horn involvement, and prolonged survival, consistent with the "mild PCH1 phenotype". PMID: 23564332
顯示更多
收起更多
-
相關疾病:Pontocerebellar hypoplasia 1B (PCH1B)
-
亞細胞定位:Cytoplasm. Nucleus, nucleolus. Nucleus.
-
蛋白家族:RRP40 family
-
數據庫鏈接:
Most popular with customers
-
-
YWHAB Recombinant Monoclonal Antibody
Applications: ELISA, WB, IHC, IF, FC
Species Reactivity: Human, Mouse, Rat
-
Phospho-YAP1 (S127) Recombinant Monoclonal Antibody
Applications: ELISA, WB, IHC
Species Reactivity: Human
-
-
-
-
-